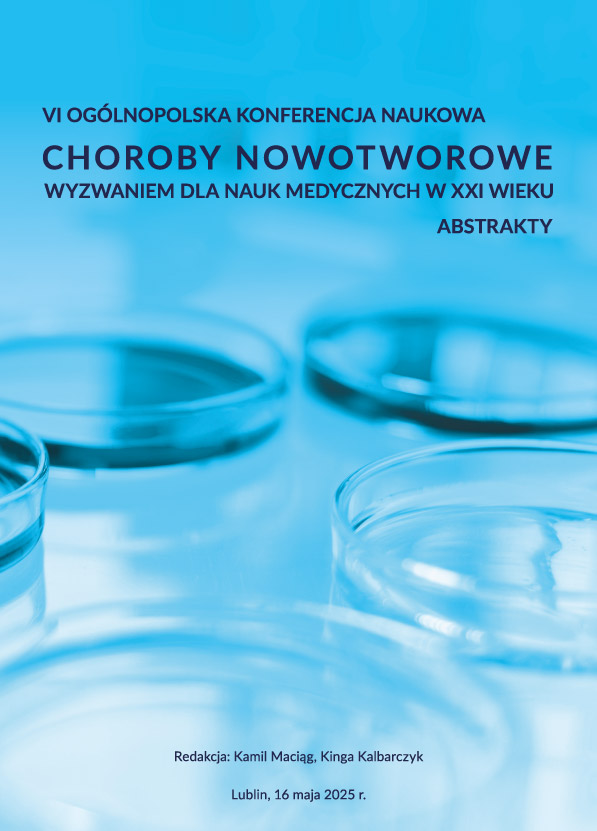

• prestiżowe interdyscyplinarne wydarzenie naukowe dla naukowców, doktorantów, studentów, pracowników oraz pasjonatów
• aktualna i ważna tematyka
• prace badawcze i przeglądowe
• wystąpienia ustne
• publikacja artykułów
• profesjonalna obsługa i organizacja wydarzenia
• uczestnictwo w formie zdalnej
Choroby nowotworowe stanowią wyzwanie dla naszego społeczeństwa. Choć w porównaniu do innych państw zachorowalność na choroby nowotworowe w Polsce nie jest wysoka to liczba osób chorych z roku na rok wzrasta, a śmiertelność u osób cierpiących na nowotwory złośliwe uważana jest za bardzo wysoką. Szansami na zmianę tego trendu jest nie tylko zwiększenie skuteczności i efektywności metod leczenia, ale również wzrost wykrywalności choroby na wczesnym etapie jej rozwoju. Osiągnięcie tego celu jest możliwe m.in. poprzez lepsze zrozumienie i pogłębienie wiedzy na temat chorób nowotworowych. Niewątpliwie ważne jest skuteczne leczenie wszystkich przypadków, niezależnie od zdiagnozowanego stadium zaawansowania. Pomimo wielu sukcesów na tym polu, konieczne jest ciągłe pogłębianie wiedzy, jak również poszukiwanie nowych i efektywnych sposobów leczenia.
Zapraszamy do udziału w konferencji poświęconej tematyce chorób nowotworowych. Podczas spotkania będziemy rozmawiać o przyczynach, diagnostyce, leczeniu, profilaktyce chorób nowotworowych, a także związanych z nimi aspektach psychologicznych i społecznych. Dynamiczny rozwój medycyny i nauk pokrewnych wpływa na znaczną poprawę jakości życia chorych i ich rodzin. Obiecujący jest również wzrost świadomości społeczeństwa na ten temat.
Do udziału w Konferencji zachęcamy naukowców, lekarzy, przedstawicieli firm oraz osoby zainteresowane tematyką chorób nowotworowych. Zapraszamy do prezentacji prac dotyczących najnowszych technologii i metod stosowanych w diagnostyce i leczeniu, kancerogenezy, substancji chemoprewencyjnych i leczniczych, opisu przypadków, psychologicznych i społecznych aspektów związanych z chorobami nowotworowymi itp.
Serdecznie zapraszamy!

Tytuł wystąpienia:
Nowotwory otrzewnej jako istotne wyzwanie w onkologii i niezaspokojona potrzeba medyczna. Dostępne metody leczenia i terapie eksperymentalne

Tytuł wystąpienia:
Podwójna rola genu BCL11B w nowotworach z komórek T

Tytuł wystąpienia:
Immunoterapia guzów litych: lekcje z infekcji wirusowych
*opłatę rejestracyjną oraz za rozdział w monografii należy uiścić w ciągu 7 dni od daty otrzymania potwierdzenia rejestracji uczestnictwa w Konferencji, jednak nie później niż 10 dni przed wydarzeniem. Brak wpłaty w podanym terminie oznacza rezygnację z udziału w wydarzeniu i usunięcie zgłoszenia z rejestracji.
**opłata dotyczy jednego wystąpienia, za każde kolejne wystąpienie obowiązuje dodatkowa opłata w wysokości 50% wniesionej kwoty opłaty konferencyjnej.
***opłata dotyczy jednego rozdziału w monografii, za każdy kolejny rozdział obowiązuje dodatkowa opłata w wysokości 399 zł.
Dane do wpłat
Fundacja na rzecz promocji nauki i rozwoju TYGIEL
ul. Głowackiego 35/348, 20-060 Lublin
NIP 946-26-49-975
Numer rachunku: 70 1140 2004 0000 3102 7533 8307
Nazwa Banku: mBank (BRE Wydz. Bankowości Elektronicznej)
Tytuły przelewów w przypadku:
– uczestnictwa bierne/czynne – nowotwory7 udział Imię i nazwisko
– uczestnictwa bierne/czynne oraz rozdziału – nowotwory7 udział+rozdział Imię i nazwisko
Prosimy o przesłanie potwierdzenia przelewu na adres: .......@fundacja-tygiel.pl w ciągu 7 dni od daty dokonania przelewu.
Faktury
Osoby zainteresowane otrzymaniem faktury proszone są o przesłanie danych (tj. nazwa, adres oraz NIP) na adres .......@fundacja-tygiel.pl w ciągu 7 dni od daty dokonania płatności.
Faktury są wystawiane wyłącznie na mailową prośbę uczestnika. Tylko tak dokonane zgłoszenie powoduje przesłanie faktury drogą elektroniczną. W przypadku pytań bądź wątpliwości prosimy o kontakt mailowy.


Wystąpienia ustne
Czynni uczestnicy Konferencji mają możliwość prezentacji swoich prac w formie wystąpień ustnych. Tematyka wystąpień musi być związana z zagadnieniami poruszanymi podczas Konferencji. Wystąpienia mogą być przygotowane zarówno na podstawie badań własnych Autora, jak też stanowić przedstawienie zagadnienia pod kątem teoretycznym.
Uczestnik może dołączyć do wystąpienia prezentację multimedialną. Prezentacja musi zostać przygotowana w języku polskim, a następnie przesłana na adres mailowy .......@fundacja-tygiel.pl w dokumencie o rozszerzeniu PDF do dnia 13 maja 2026 roku. Dzięki temu zostanie sprawdzona poprawność odczytu prezentacji. Dokument z prezentacją należy nazwać zgodnie ze wzorem „Nazwisko i Imię, nowotwory7, pierwsze 3 słowa z tytułu wystąpienia”.
Czas wystąpienia: 15 min.
Przydatne informacje dotyczące zgłoszenia abstraktów:
• abstrakty wystąpień ustnych należy zgłaszać za pośrednictwem formularza elektronicznego do dnia 7 maja 2026 r.,
• tytuły prac oraz ich abstrakty powinny być przygotowane w języku polskim,
• długość jednego abstraktu to 1500 do 2000 znaków ze spacjami,
• abstrakt powinien zostać napisany w formie bezosobowej i aspekcie dokonanym,
• treść abstraktu to odpowiedź na podstawowe pytania: Jaki jest cel pracy? Co w niej przedstawiono?
– należy opisać zakres tematyczny opracowania,
– wymienić główne metody użyte w opracowaniu,
– wyjaśnić, co wynika z przeprowadzonej analizy, dyskusji oraz uzyskanych wyników,
– podać główne wnioski oraz ewentualne założenia badawcze do dalszych prac lub zastosowania praktyczne,
• wystąpienia ustne mogą mieć maksymalnie 3 autorów (istnieje możliwość odstępstwa, jednak po uprzednim zgłoszeniu tego na adres .......@fundacja-tygiel.pl i uzyskaniu jednoznacznej zgody Komitetu Organizacyjnego).


Informacje ogólne
W ramach uczestnictwa w wydarzeniu proponujemy Państwu możliwość opublikowania swoich prac naukowych w formie rozdziału w monografii naukowej (po publikacji prace będą dostępne w formie open access). Wydane monografie, spełniają kryteria uwzględniane przy ocenie ewaluacyjnej dorobku naukowego, a także są satysfakcjonującym sposobem przedstawienia swojej wiedzy.
Wydawca publikacji:
Monografia zostanie wydana nakładem Wydawnictwa Naukowego TYGIEL, które zostało ujęte w wykazie wydawnictw publikujących recenzowane monografie naukowe, zgodnie z komunikatem Ministra Edukacji i Nauki z dnia 22 lipca 2021 r., który dostępny jest >>tutaj<<.
Zgłoszenie rozdziału:
• w formularzu rejestracji uczestnictwa należy zaznaczyć deklarację chęci opublikowania rozdziału w monografii naukowej;
• dostarczenie do biura Fundacji TYGIEL (ul B. Głowackiego 35/348, 20-060 Lublin) oświadczenia autorów z oryginalnymi podpisami wszystkich współautorów pracy oraz takim samym tytułem, jaki został podany w przesłanej wersji elektronicznej. Na kopercie prosimy o dopisanie nazwy wydarzenia (druk Oświadczenia Autorów do pobrania >>tutaj<<);
• przesłanie mailowo na adres .......@fundacja-tygiel.pl rozdziału zgodnego z ustalonym wzorem formatowania: przypisy końcowe (UWAGA, prosimy o korzystanie z aktualnej wersji do pobrania >>tutaj<<);
• uwzględnienie ewentualnych wskazówek edytorskich i technicznych wskazanych przez Organizatora.
Autorzy są zobligowani do przesłania pracy zgodnie z datą podaną na stronie wydarzenia w zakładce Terminy. W przypadku wystąpienia opóźnień w przygotowaniu rozdziału, skutkujących nieprzesłaniem pracy w terminie, prosimy o wcześniejszy kontakt mailowy w celu podjęcia indywidualnych ustaleń. Niedotrzymanie terminu może spowodować opóźnienie w publikacji.


Konferencja odbędzie się za pośrednictwem Platformy ClickMeeting. Pozwoli ona na udział w wydarzeniu poprzez urządzenia mobilne, takie jak: laptop, smartfon, tablet, komputer stacjonarny (uczestnikom czynnym rekomendujemy, aby podczas przedstawiania prezentacji korzystali z komputera stacjonarnego, laptopa lub aplikacji mobilnej ClickMeeting).
Funkcjonalność platformy:
• możliwość wystąpienia dwóch Prelegentów jednocześnie,
• podjęcie dyskusji po wystąpieniu w formie czatu,
• udostępnienie możliwości zabrania głosu wybranym Uczestnikom Wydarzenia,
• obecność i ciągłe wsparcie Organizatorów,
• wyświetlenie prezentacji przez Prelegenta oraz możliwość rysowanie po slajdach,
• udostępnianie ekranu przez Prelegenta w trakcie wystąpienia.
Aby bez przeszkód móc uczestniczyć w wydarzeniu użytkując platformę ClickMeeting wystarczy dostęp do Internetu i aktualna przeglądarka internetowa (Chrome, Opera, Firefox, Edge). Zaleca się używać komputer z 4-wątkowym procesorem, min. 8 GB pamięci RAM i aktualnym systemem operacyjnym Windows 8.1, Windows 10 lub Windows 11. W praktyce jednak wystarczy dowolny sprzęt, który płynnie wykonuje zadania biurowe. Platforma streamingowa działa także na systemach operacyjnych Apple oraz dystrybucjach Linux, w tym – systemie Android i ChromeOS.
W celu sprawnego przebiegu Konferencji zorganizujemy testy dla uczestników (najpóźniej dzień przed wydarzeniem). Ze swojej strony zapewniamy pomoc techniczną w konfiguracji, jak również wsparcie ze strony przedstawicieli platformy.
Wystąpienie online nie jest łatwe i często bywa stresujące nawet dla profesjonalistów. Dlatego przygotowaliśmy dla Państwa kilka wskazówek, których wdrożenie pozwoli na jeszcze bardziej owocny udział poprzez zwiększenie komfortu osoby prezentującej, jak i pozostałych uczestników.
Zachęcamy do zapoznania się z >>tym<< materiałem, który jest dostępny także w zakładce Do pobrania.
Każda osoba zainteresowana udziałem w Konferencji zobligowana jest do rejestracji uczestnictwa poprzez dostępny poniżej formularz rejestracji uczestnictwa.
Przedłużona tura rejestracji trwa do 6 maja 2025 r.
Rejestracja uczestnictwa w Konferencji -> kliknij tutaj
Uczestnicy, którzy planują przygotować wystąpienia ustne są zobligowani do zarejestrowania jego tytułu i abstraktu poprzez formularz.
Rejestracja tytułów i abstraktów wystąpień -> kliknij tutaj
Rejestracja uczestnictwa -> kliknij tutaj
Rejestracja tytułów wystąpienia i abstraktów -> kliknij tutaj

Fundacja na rzecz promocji nauki i rozwoju TYGIEL
e-mail: .......@fundacja-tygiel.pl
tel.: 733 933 ...
ul. Głowackiego 35/348, 20-060 Lublin
NIP: 946-26-49-975
REGON: 061730828
KRS: 0000524667
Konto bankowe PL – mBank:
70 1140 2004 0000 3102 7533 8307
EUR account: PL02 1140 2004 0000 3312 1237 8057
USD account: PL08 1140 2004 0000 3712 1253 7124